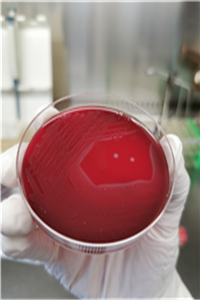
圖片2.png 圖片2.png

李斯特菌,你了解嗎?
日 期:2019-06-17 16:44:45 瀏覽:(3266)
34歲的段女士是一位幸福的二胎孕媽,有了之前懷孕的經(jīng)驗,她顯得自如很多,不像其他新手準(zhǔn)媽媽們那樣小心翼翼、謹(jǐn)小慎微,整個孕期,她的身體狀況也比較好。
6月3日晚上,段女士在家中時忽然感到發(fā)熱、惡心、腹痛,在家人的陪同下,她立刻來到西電集團(tuán)醫(yī)院產(chǎn)科就診。產(chǎn)科值班醫(yī)生郭利佩在詢問段女士的情況時,得知她在一小時前吃了冰箱里存放的過夜剩菜,郭醫(yī)生立即為她進(jìn)行各項血液檢查。經(jīng)檢查,段女士的各項感染指標(biāo)均明顯升高。次日清晨,產(chǎn)科主任賈小文迅速召集醫(yī)院感控科、藥劑科、消化內(nèi)科、新生兒科等多個相關(guān)科室進(jìn)行多學(xué)科會診,根據(jù)產(chǎn)婦的實際情況,綜合各科室的會診意見,完善血培養(yǎng),并為患者更換輸液頭孢三代抗生素。

孕媽臨產(chǎn)在即,輸入的大量抗生素對腹中的胎兒產(chǎn)生了不可預(yù)知的危害,無奈之下,患者及家屬要求放棄胎兒,全力救治孕婦。6月4日15:20,段女士分娩出一死胎,產(chǎn)科將胎盤送病檢,結(jié)果為急性絨毛膜羊膜炎,血培養(yǎng)結(jié)果為李斯特菌,經(jīng)過氨芐西林抗感染治療,段女士恢復(fù)良好,痊愈出院。
血培養(yǎng)回報的李斯特菌到底是一種什么病菌呢,它的危害是什么,該如何預(yù)防......讓我們一起來認(rèn)識一下李斯特菌。

李斯特菌,又名單核球增多性李斯特菌,是一種革蘭氏陽性、兼性厭氧桿菌,它耐酸耐堿耐低溫,主要以食物為傳染媒介,是最致命的食源性病原體之一 。
1、李斯特菌是如何感染到人的?

李斯特菌主要是通過口腔—糞便途徑進(jìn)行傳播,人們通過食入冷凍食品、生鮮奶、和未洗凈的水果蔬菜等而感染,約85-90%的病例是由被污染的食品引起的。孕婦感染后通過胎盤或產(chǎn)道感染胎兒或新生兒。
2、哪些人是易感人群?
易感人群主要與免疫力降低有關(guān),如妊娠期婦女、新生兒、老年人及處于免疫抑制狀態(tài)的患者。
3、感染李斯特菌后的臨床表現(xiàn)是什么?
早期感染癥狀類似流感,比如發(fā)熱、肌肉酸痛、惡心、嘔吐,伴有胃腸道不適、腹痛、腹瀉等癥狀。隨著細(xì)菌侵襲神經(jīng)系統(tǒng)和血液系統(tǒng),可逐漸出現(xiàn)腦膜炎、心內(nèi)膜炎、菌血癥、敗血癥等嚴(yán)重并發(fā)癥。
孕婦感染后可能發(fā)生流產(chǎn)、胚胎停育、胎死宮內(nèi)、早產(chǎn)、新生兒肺炎、敗血癥、細(xì)菌性腦膜炎等,新生兒病死率高達(dá)25%~30%。
4、感染李斯特菌后,如何進(jìn)行有效治療?
目前在治療李斯特菌感染的抗菌藥物選擇上,以氨芐青霉素為最佳首選藥物,無羊膜炎或恢復(fù)期患者可口服阿莫西林,療程10-14天。
5、如何預(yù)防李斯特菌感染?

在處理冰箱中的日常食材中,我們做到“生熟分開、保持清潔、燒熟煮透、安全溫度、安全原料”五個原則就會基本告別李斯特菌了。
(產(chǎn)科 供稿)